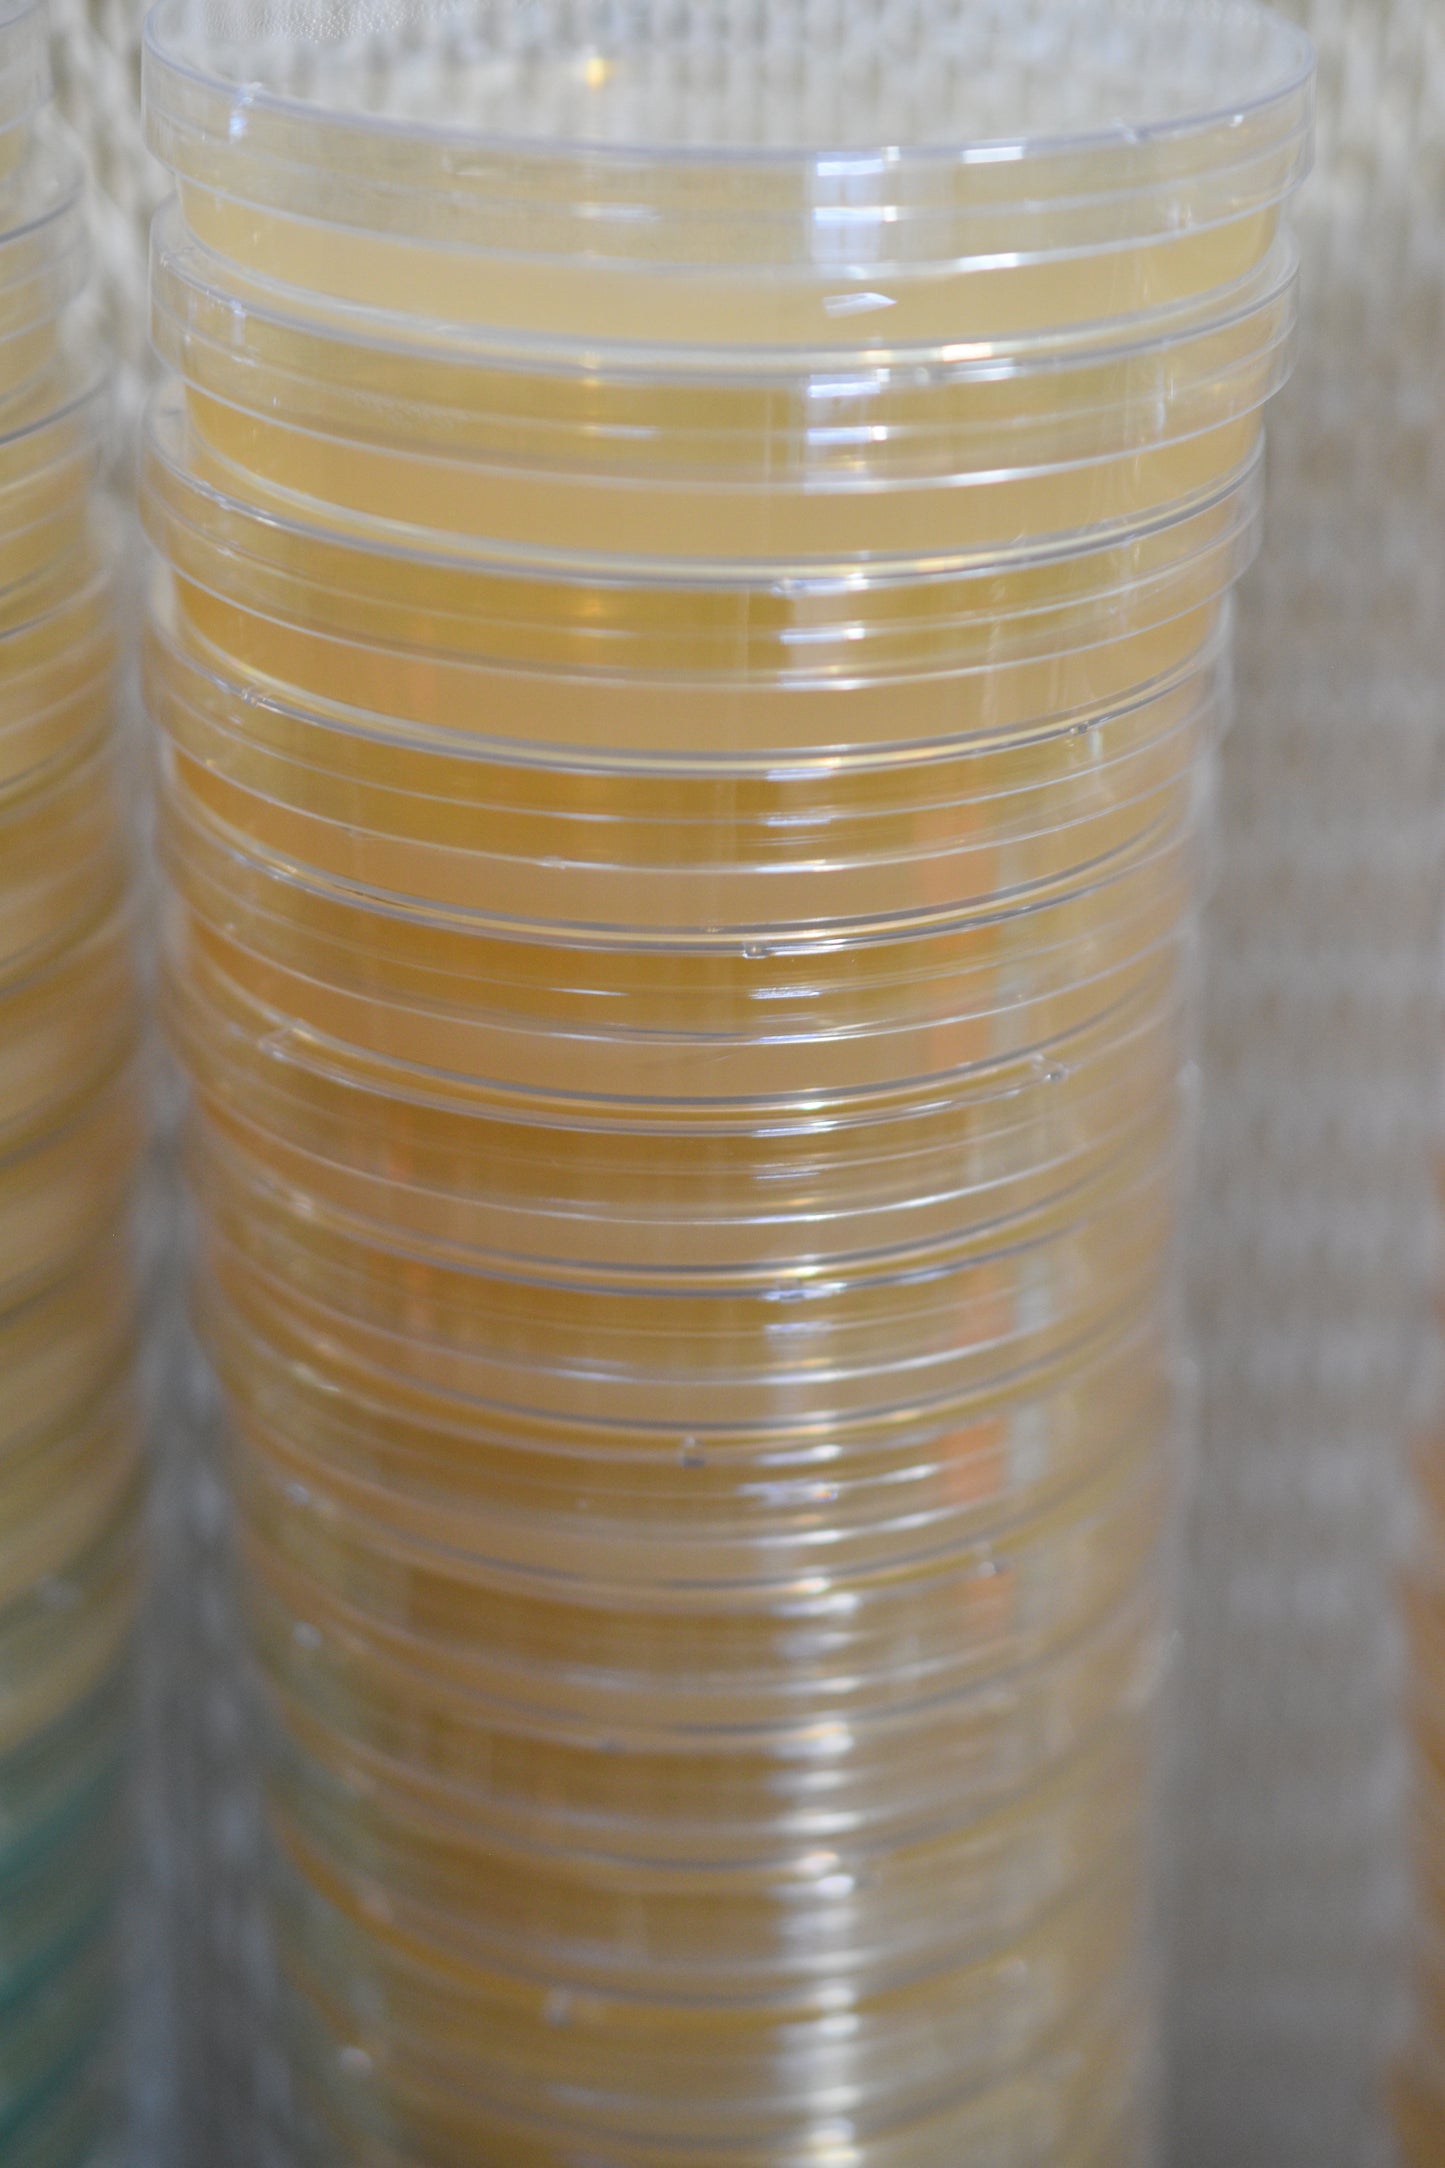

Agar Plates (10 Pack)
Regular price
$10.00 USD
Regular price
Sale price
$10.00 USD
Unit price
per
Shipping calculated at checkout.
Couldn't load pickup availability
Colorless Plain Agar Plates (10-Pack)
Our Colorless Plain Agar Plates are the perfect foundation for your microscopy and cultivation projects. Each pack contains 10 sterile 100mm x 15mm Petri dishes, filled with a nutrient-rich, transparent medium for easy observation of growth patterns.
Key Features for optimal nutrient support!
Media Composition:
- Organic Malted Barley Extract
- Himedia Agar
Sterile & Ready-to-Use: Convenient and contamination-free
Ideal for microscopy enthusiasts and cultivators seeking high-quality, reliable agar plates for their research.